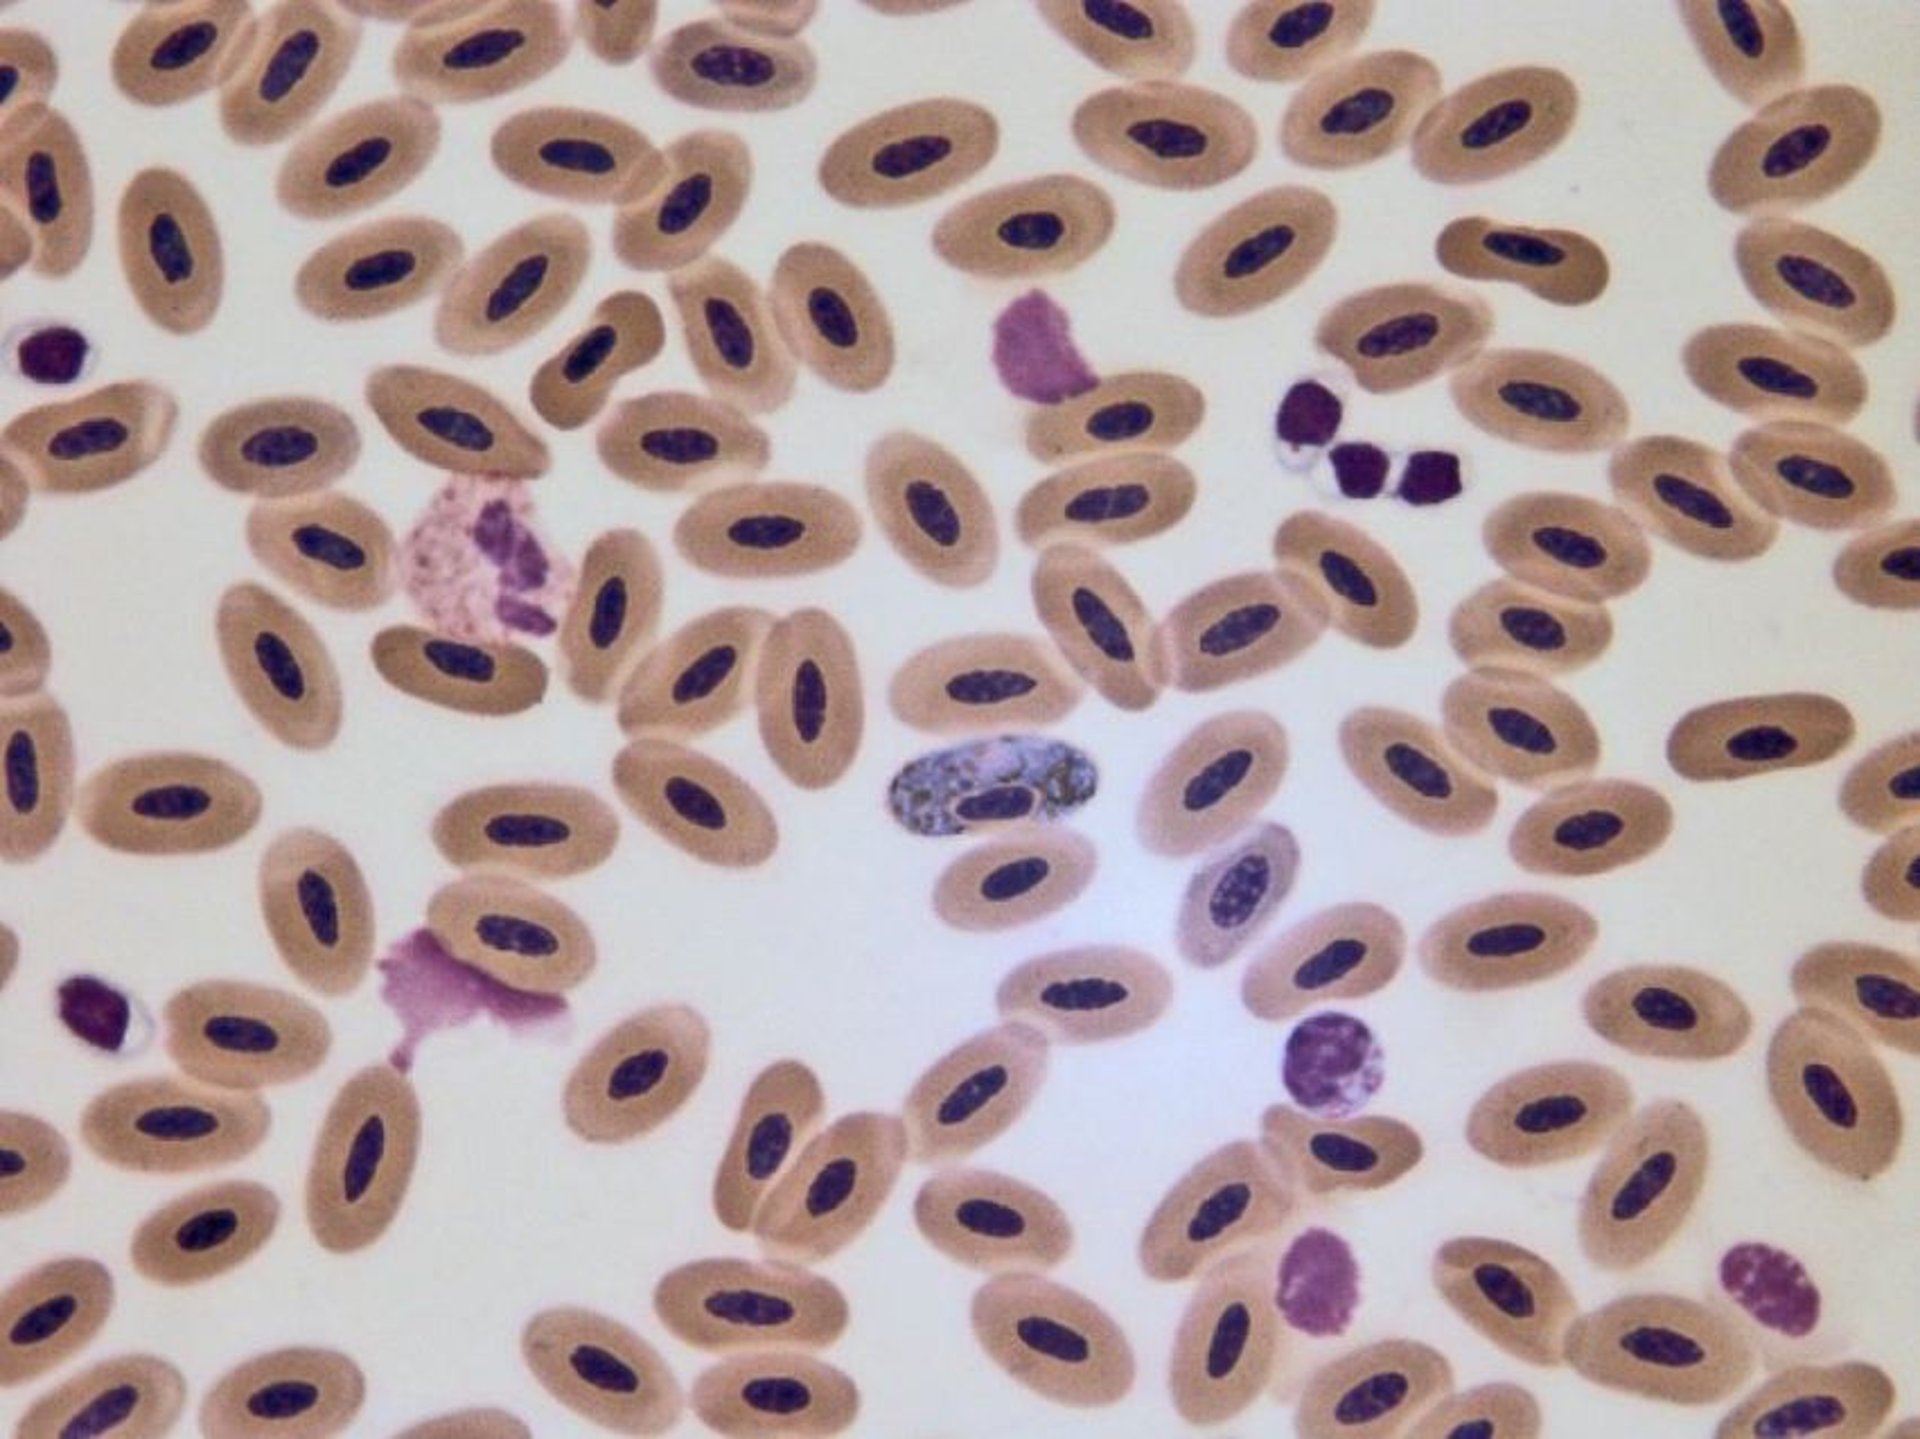
<i >Hemoproteus</i>, microfotografía, sangre, ganso

Hemoproteus, microfotografía, sangre, ganso
Microfotografía que muestra a Haemoproteus en un frotis de sangre de un ganso canadiense (Branta canadensis). Los gametocitos pigmentados se curvan alrededor del núcleo de un eritrocito maduro. Aumento original 1000X.
Cortesía de la Dra. L. A. Degernes.
En estos temas